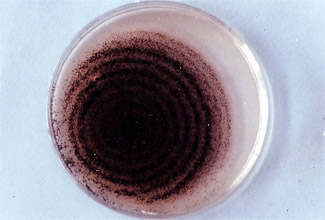
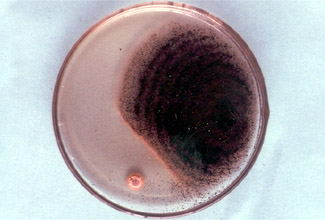
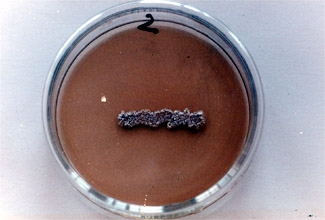
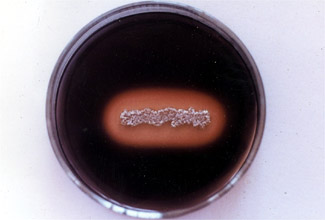

|
|
 |
 |
■大師道−(1)
|
昭和52年から53年にかけて、垂水中学校の活動で、中央区の大竜寺へむかう大師道のスダジイ林の土壌から、クモノスカビを栄養として吸収する放線菌を分離した。 |
|
|
|
| クモノスカビ:培養5日目。 |
光線金がクモノスカビを溶かして吸収している。下左の白い点が放線菌。 |
|
|
| この放線菌をポテト培地に植え7日がたった。 |
左のものにヨウ素液をかけると放線菌のまわりにはデンプンがないことがわかる。 |
 |
 |
| 放線菌を植え10日から14日たってヨウ素液をかけると、まわりにはデンプンがなく残っているデンプンの縁が消化されて赤く染まるデキストリンになっています。 |
スダジイ林(平成17年2月現在) |
|
| 大師道の地図に戻る |
|
|